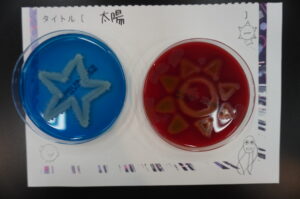
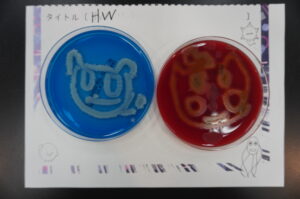
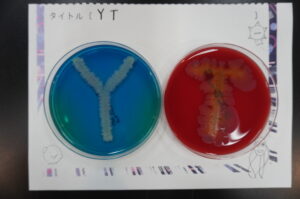
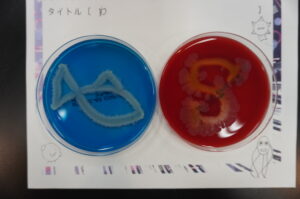
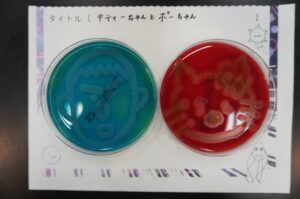
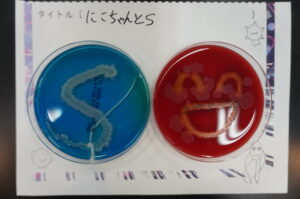
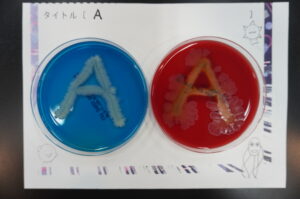
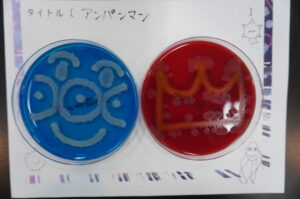
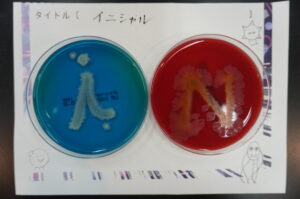
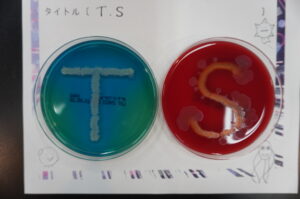
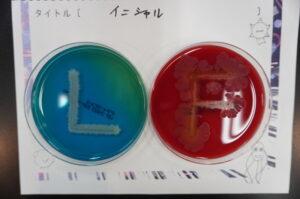
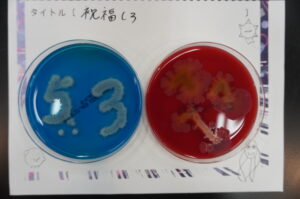
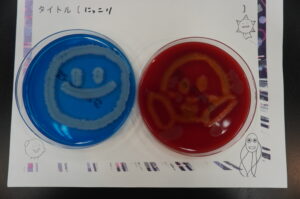
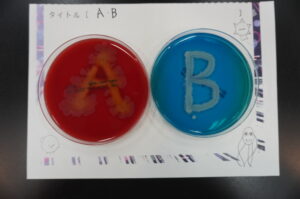
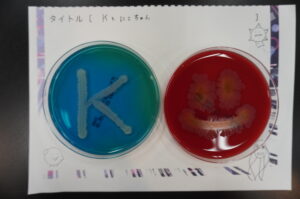
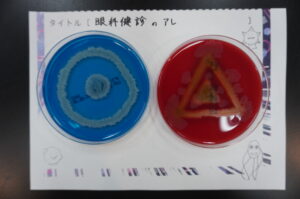
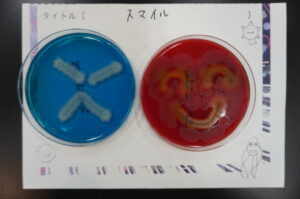
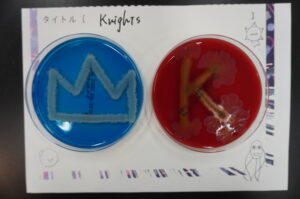
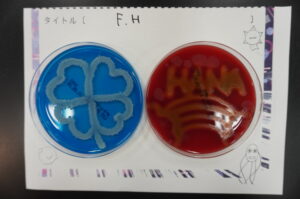
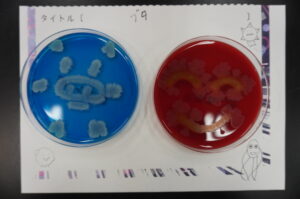

NEWS
お知らせ
お知らせ
出張オープンキャンパスin名古屋 納豆菌アート作品
2023年4月23日に出張オープンキャンパスin名古屋で行われた『納豆菌アート(納豆菌で絵を描いてみよう~!)』に
参加いただきありがとうございました。
参加したみなさんの納豆菌アートが出来上がりましたので、作品を公開します!
感想・ご意見等ありましたら下記の連絡先までお寄せください。
臨床検査学科 中山 章文
anakayama@u-gifu-ms.ac.jp
2023年4月23日に出張オープンキャンパスin名古屋で行われた『納豆菌アート(納豆菌で絵を描いてみよう~!)』に
参加いただきありがとうございました。
参加したみなさんの納豆菌アートが出来上がりましたので、作品を公開します!
感想・ご意見等ありましたら下記の連絡先までお寄せください。
臨床検査学科 中山 章文
anakayama@u-gifu-ms.ac.jp